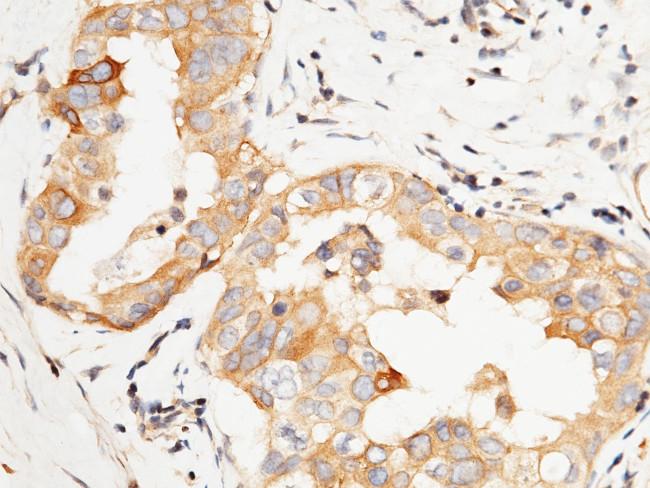
PTP1B Antibody in Immunohistochemistry (Paraffin) (IHC (P))

Search
Invitrogen
PTP1B Polyclonal Antibody
{{$productOrderCtrl.translations['antibody.pdp.commerceCard.promotion.promotions']}}
{{$productOrderCtrl.translations['antibody.pdp.commerceCard.promotion.viewpromo']}}
{{$productOrderCtrl.translations['antibody.pdp.commerceCard.promotion.promocode']}}: {{promo.promoCode}} {{promo.promoTitle}} {{promo.promoDescription}}. {{$productOrderCtrl.translations['antibody.pdp.commerceCard.promotion.learnmore']}}
产品信息
PA5-118220
宿主/亚型
分类
类型
抗原
偶联物
形式
保存条件
运输条件
靶标信息
PTP1B (PTPN1) is a tyrosine-protein phosphatase which acts as a regulator of endoplasmic reticulum unfolded protein response. It mediates dephosphorylation of EIF2AK3/PERK and in turn inactivates the protein kinase activity of EIF2AK3/PERK. PTP1B also plays a role in CKII- and p60c-src-induced signal transduction cascades. It regulates the EFNA5-EPHA3 signaling pathway which modulates cell reorganization and cell-cell repulsion. PTP1B also regulates the hepatocyte growth factor receptor signaling pathway through dephosphorylation of MET.
仅用于科研。不用于诊断过程。未经明确授权不得转售。